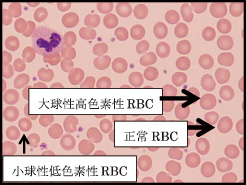
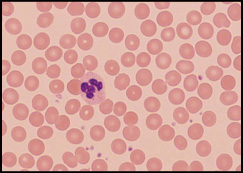
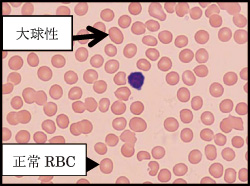

=== 随筆・その他 ===
|
どうしても「疲れがとれない」
「血液像報告を参考に」 |
東区・郡元支部
(デイジークリニック) 武元 良整 |
|
青壮年の世代でも「疲れがとれない」を訴えて来院されることがあります。多くは睡眠不足が背景にあります。女性では,貧血症状はないか?男性なら飲酒などにともなう肝機能障害は?などと一般的な理由を考えます。そして,朝の起床困難などあれば,男女を問わず,うつ状態初期の可能性などもあり複雑です。幸い,「貧血外来」では,末梢血標本の顕微鏡による観察を鹿児島市医師会臨床検査センター「血液検査室」に依頼していますので,数日後には血液像所見として,赤血球の大小不同1+,多染性1+などの報告から隠れた鉄欠乏性貧血を疑い,低フェリチンがあれば「かくれ貧血」で確定診断となります。または「大球性」と頭痛・たちくらみから,ビタミンB12欠乏と診断する事もあります。したがって,顕微鏡下での血液像観察は「疲れがとれない」という時の病態解明の一助となります。クリニックに顕微鏡はありません。血液検査室の技師による血液像の報告をもとに「疲労感」の訴えで来院した2症例の原因が「ビタミンB12欠乏」と判明したので報告致します。
症 例 1 :40歳,女性
主 訴:どうしても疲れがとれない。
背 景: 飲食業,週に2日間は昼間の勤務あり。睡眠不足あり。喫煙歴は20年,8本/日。飲酒は2週に1回程度。
病 歴:生活が不規則で,夜の飲食店勤務では午前2時頃帰宅,寝付き不良,便秘傾向。
理学所見: 血圧102/68,身長152.0cm,体重42.0kg,理学所見で貧血,黄疸なし。
末梢血検査:CBC(complete blood count:全血球計算)では貧血なし,軽度の大球性。
| 検査結果 |
| RBC:439万/μL,Hb:14.4g/dL,MCV (mean corpuscular volume:平均赤血球容積):93.8f L,MCH(mean
corpuscular hemoglobin:平均赤血球血色素値):32.8pg,PLT(血小板数):42.4万/μL |
|
末梢血液像:RBC形態は大小不同を軽度に認める。
(末梢血液画像は鹿児島市医師会臨床検査センター血液検査室へ依頼し撮影いただきました) |
血液生化学検査:血液生化学で肝腎機能正常範囲,脂質異常症も認めず。血液像の観察では小球性低色素性RBCを標本上に10%程度認める。血清フェリチン値は正常範囲(73.3ng/mL)。ビタミンB12欠乏を示唆する大球性赤血球が少数みられ,血清ビタミンB12値は157pg/mL(基準値180-914)と著明に低値。葉酸値は5.5ng/mL(基準値4以上)。
治 療:治療はビタミンB12静注で開始した。葉酸も造血亢進にともなう消耗が見込まれるため1カ月間の内服とした。
最終診断:ビタミンB12欠乏症(ビタミンB12:157pg/mL)
治療経過:ビタミンB12静注により5-6回終了後から倦怠感は消失 。
1カ月後のCBCは不変。しかし,末梢血液像は大小不同などが消失改善(図2)。
|
末梢血液像:RBC形態の大小不同と多染性はほぼ消失。ごく軽度に認めるのみ。
(末梢血液画像は鹿児島市医師会臨床検査センター血液検査室へ依頼し撮影いただきました) |
| 検査結果 |
| RBC:442万/μL,Hb:14.4g/dL,MCV:93.9f L,MCH:32.6pg,PLT:41.3万/μL |
症 例 2 :29歳,女性
主 訴: 冷え症,生理不順,頭痛,胃の調子不良。
現 病 歴:以前から易疲労感,朝起きづらい,集中力が低下する事あり,時々頭痛あり,X年1月に初診。
背 景:非喫煙・機会飲酒,アレルギー歴なし,しもやけできやすい。
理学所見:身長150.2cm,体重45.4kg,眼瞼結膜に貧血なく,黄疸も認めない。
漢方問診:疲れやすく日中に眠気がある(気虚),体が重い,たちくらみあり,むくみやすい(水滞),生理痛,こむらがえりもある。皮膚がカサカサしている。目が疲れる(血虚)。
漢方腹証:左臍傍痛あり。
末梢血検査:CBCは貧血なし。
血液生化学検査:職場健診で血液検査異常なし。血清ビタミンB12値は121pg/mL(基準値180-914)と著減,葉酸値7.2ng/mL(基準値4以上)。
| 検査結果 |
| RBC:425万/μL,Hb:13.5g/dL,MCV:92.0f L,MCH:31.8pg,PLT:21.0万/μL |
|
図 3 末梢血液像:RBC形態はほぼ正常範囲。
(末梢血液画像は鹿児島市医師会臨床検査センター血液検査室へ依頼し撮影いただきました) |
臨床経過:漢方的に「当帰四逆加呉茱萸生姜湯」内服継続1カ月にて冷え改善。ビタミンB12静注5回終了頃から倦怠感は改善した。
最終診断:ビタミンB12欠乏症(ビタミンB12:121pg/mL)
まとめ:巨赤芽球性貧血(悪性貧血など)がビタミンB12欠乏症の代名詞です1)。その特徴的所見は教科書的にはCBCでMCV値100から120と記載されています。今回の2症例ともにビタミンB12値は著減し,臨床症状も「疲労感」「頭痛」「朝,起床困難」など典型的な「ビタミンB12低下の徴候」でした2)。しかし,2例共にMCV92から93程度でした。MCVが120程度にまで高値になるのは典型的な「悪性貧血」と考えた方が良いでしょう。MCV値よりも血液像から大球性赤血球の存在を確認し「倦怠感」の臨床症状から,ビタミンB12の低下を疑い検査。その低値を確認し治療開始し症状改善に有用であった2症例を報告致しました。
文 献
1. Rapaport SI“Introduction to Hematology”second edition,JB Lippincott Company 1987.
2. 武元良整:「倦怠感・たちくらみ」とビタミンB12欠乏。鹿児島市医報第56巻第2号(通巻660号):66-67,2017

|
|
このサイトの文章、画像などを許可なく保存、転載する事を禁止します。
(C)Kagoshima City Medical Association 2017 |